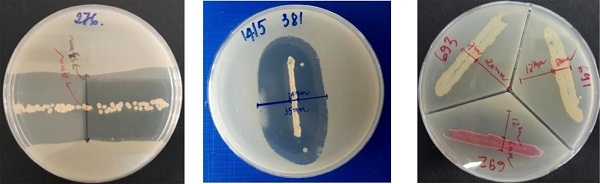

Đánh giá hoạt động ức chế của vi khuẩn xạ khuẩn đối với chủng Vibrio Parahaemolyticus nguyên nhân gây bệnh hoại tử gan cấp tính (AHPND) trên tôm Thẻ chân trắng (Penaeus vannamei)
Vào năm 2013, các plasmid độc lực của chủng V. parahaemolyticus đã được nhận định [...]
16
Th9
Th9
Phát triển thiên địch là xu hướng trong các biện pháp bảo vệ cây trồng
Việc sản xuất rau sạch, rau an toàn trong nông nghiệp đô thị đã trở [...]
06
Th4
Th4
- 1
- 2